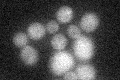
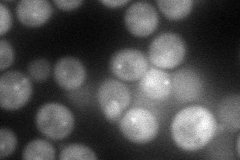
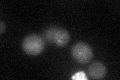

View description
Essential component of the MIND kinetochore complex (Mtw1p Including Nnf1p-Nsl1p-Dsn1p) which joins kinetochore subunits contacting DNA to those contacting microtubules; critical to kinetochore assembly
Localization:
Intensity:
Fold change:
Significance:
-
C’ GFP library in SD
below threshold16.61 -
N' NOP1pr-GFP in SD

cytosol,punctate67.4903 -
N' TEF2pr-mCherry in SD
punctate81.1109 -
N' NATIVEpr-GFP in SD

punctate24.7813 -
N' TEF2pr-VC and Cyto-VN in SD

#N/A0 -
C’ GFP library in SD+DTT
cytosol16.641No -
C’ GFP library in SD+H2O2

cytosol15.220.91No -
C’ GFP library in Starvation Media

cytosol14.810.89No -
C’ GFP library on the background of Pup2-DaMP

below threshold -
C’ GFP library on the background of CCT mutant

below threshold17.75471.06792No
